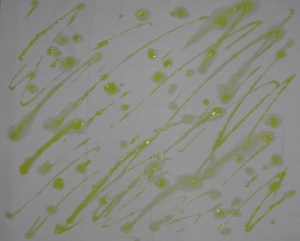

While organizing my craft room, I recently came across some left over yarn from one of the scarves I posted about last year. Many of the scarves I have made were done to use up yarn that has been in my craft room for years. Since I really don’t need any more scarves, this past year I have been putting together matching winter wear sets to donate.
While organizing my craft room, I recently came across some left over yarn from one of the scarves I posted about last year. Many of the scarves I have made were done to use up yarn that has been in my craft room for years. Since I really don’t need any more scarves, this past year I have been putting together matching winter wear sets to donate.
Having found a small bit of the black boa yarn, I looked on-line to see if I could find the red that I had used when making the scarf last February. I was fortunate to find some on eBay. With shipping, it was less than $5 for the skein that I needed. So, I ordered the yarn and made a hat to match the scarf. I will be adding a pair of black waterproof gloves to the set before I donate them.
 Since the yarn had lots of texture, these were easy to make – simply just knit stitches. If you want to make a set for your self, I would suggest knitting the hat first. This will minimize the amount of yarn left over. Because the yarn is very slippery, I would recommend plastic needles rather than metal. In my experience, the metal needles allow the stitches to slip off the needle too easily.
Since the yarn had lots of texture, these were easy to make – simply just knit stitches. If you want to make a set for your self, I would suggest knitting the hat first. This will minimize the amount of yarn left over. Because the yarn is very slippery, I would recommend plastic needles rather than metal. In my experience, the metal needles allow the stitches to slip off the needle too easily.
Materials
1 skein black boa yarn
3 skeins red yarn
Size 9 circular knitting needles (24” length)
Blunt-end Tapestry needle
Gauge: 14 sts and 17 rows = 4”
Hat:
Using black yarn, cast on 76 stitches and knit 17 rows. Switch to red yarn and knit one row. At the end of the row, making sure that the black section is not twisted, continue knitting in a circular fashion. Knit a total of 45 rows with the red yarn. Cast off, leaving a long tail of yarn. Using the tapestry needle, thread the yarn through each of the cast off stitches. Gather up the knitting to form the crown of the hat and tie off. Using the black yarn tail at the beginning of the knitting, join the edges of the black band.
Scarf (approximately 72″):
Using a full skein of the red yarn, cast on 250 stitches. Working in circular fashion, knit until the entire skein is used. Switch to the black yarn left over from knitting the hat and knit until that skein is used up. Switch to the other full skein of red yarn and knit until about 250 inches of yarn remains. Cast off. Weave in all ends of the yarn.
If you do make a hat and/or scarf with the pattern, please post a picture of your results in the comments – I would love to see what you make.










 While organizing my craft room, I recently came across some left over yarn from one of the
While organizing my craft room, I recently came across some left over yarn from one of the  Since the yarn had lots of texture, these were easy to make – simply just knit stitches. If you want to make a set for your self, I would suggest knitting the hat first. This will minimize the amount of yarn left over. Because the yarn is very slippery, I would recommend plastic needles rather than metal. In my experience, the metal needles allow the stitches to slip off the needle too easily.
Since the yarn had lots of texture, these were easy to make – simply just knit stitches. If you want to make a set for your self, I would suggest knitting the hat first. This will minimize the amount of yarn left over. Because the yarn is very slippery, I would recommend plastic needles rather than metal. In my experience, the metal needles allow the stitches to slip off the needle too easily. Knit Swirl Scarf
Knit Swirl Scarf